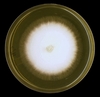

unit 2 images Flashcards
(18 cards)
1
Q

A
penicilllium spps
2
Q

A
Microsporum Canis( Macroconidia)
3
Q

A
Aspergilus fumigatus
4
Q

A
aspergillus fumigutus
5
Q

A
Aspergillus fumigatus
6
Q

A
coccidioides immitis
7
Q

A
coccidioides immitis
8
Q

A
Cryptococcus neoformans
9
Q

A
C.neoformans on bird seed agar
10
Q

A
C.neoformans on Sabouraud’s dextrose agar
11
Q

A
Candida albicans on cornmeal agar
12
Q

A
Candida albicans
13
Q

A
Candida ablicans in germ tube
14
Q

A
yeast colonies of Candida ablicans
15
Q

A
Dematiaceous Moulds
fungi that produce dark brown, green-black, or black colonies
16
Q
A
hyaline mold colonies on sab-dex agar
colonies may be colourless or brightly coloured
17
Q
what is this
which is the preffered agar
what subtrate is used up

A
api20c
cornmeal agar
carbohydrate
18
Q
A